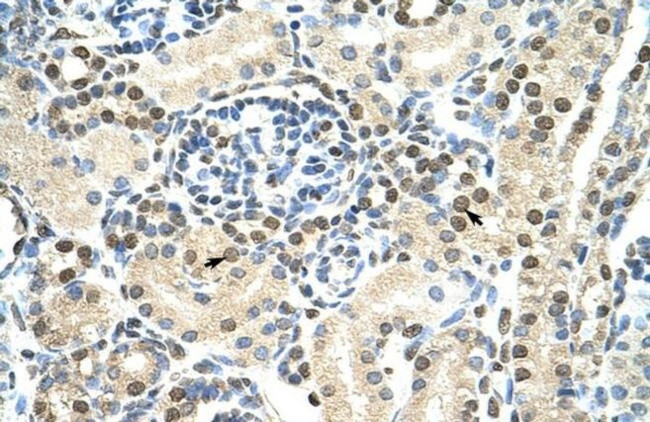
DAZAP1 Antibody in Immunohistochemistry (Paraffin) (IHC (P))

Search
Invitrogen
DAZAP1 Polyclonal Antibody
{{$productOrderCtrl.translations['antibody.pdp.commerceCard.promotion.promotions']}}
{{$productOrderCtrl.translations['antibody.pdp.commerceCard.promotion.viewpromo']}}
{{$productOrderCtrl.translations['antibody.pdp.commerceCard.promotion.promocode']}}: {{promo.promoCode}} {{promo.promoTitle}} {{promo.promoDescription}}. {{$productOrderCtrl.translations['antibody.pdp.commerceCard.promotion.learnmore']}}




Please note: We are reviewing Western blot images included in the antibody testing data in our catalog, including those provided by third parties. Unless expressly labeled or annotated as “raw-unedited”, Western blot images included in the antibody testing data in our catalog may have been edited, optimized or otherwise adjusted for presentation.
产品信息
PA5-41886
种属反应
宿主/亚型
分类
类型
抗原
偶联物
形式
浓度
规格
纯化类型
保存液
内含物
保存条件
运输条件
RRID
产品详细信息
Peptide sequence: LAFPPPPSQA APDMSKPPTA QPDFPYGQYA GYGQDLSGFG QGFSDPSQQP
Sequence homology: Dog: 86%; Guinea Pig: 86%; Horse: 93%; Human: 100%; Mouse: 100%; Rat: 93%; Zebrafish: 79%
靶标信息
The androgen receptor (AR) is a member of the steroid-hormone receptor superfamily of nuclear receptors. The receptor is more than 90 kDa and has three major functional domains: the N-terminal domain, DNA-binding domain, and the androgen-binding domain. The androgen receptor is a ligand-activated transcription factor that binds active testosterone (T) and dihydrotestosterone (DHT). Upon binding the hormone ligand, the receptor dissociates from accessory proteins, translocates into the nucleus, dimerizes, and then stimulates transcription of androgen responsive genes. The AR signaling pathway plays a key role in development and function of male reproductive organs, including the prostate and epididymis.AR also plays a role in nonreproductive organs, such as muscle, hair follicles, and brain.Androgen Receptor is a phosphoprotein, and also regulates mitogen-activated protein kinase (MAP kinase). The inhibition of the MEK1/2 pathway correlates directly with a change in phosphorylation state of the androgen receptor. Abnormalities in the AR signaling pathway have been linked to a number of diseases, including prostate cancer, Kennedy's disease, and male infertility. Mutations in this gene are associated with complete androgen insensitivity (CAIS).
仅用于科研。不用于诊断过程。未经明确授权不得转售。
篇参考文献 (0)
生物信息学
蛋白别名: MGC19907